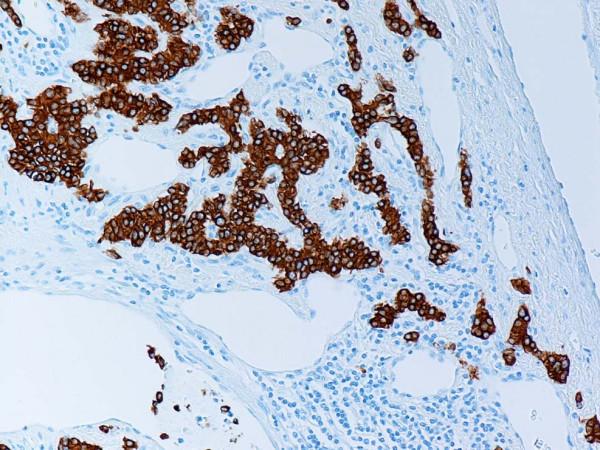

胃的复合印戒细胞/神经内分泌癌伴神经内分泌癌转移成分:一种预后较好的实体瘤。
Composite signet-ring cell/neuroendocrine carcinoma of the stomach with a metastatic neuroendocrine carcinoma component: a better prognosis entity.
机构信息
Department of Pathology, University of Maryland Medical Center, 22 S. Greene Street, Baltimore, MD 21201, USA.
出版信息
Diagn Pathol. 2007 Nov 7;2:43. doi: 10.1186/1746-1596-2-43.
BACKGROUND
Mixed (composite) exocrine-neuroendocrine cell carcinomas are defined as an intimate admixture of neoplastic glandular exocrine and neuroendocrine cell types. Although gastric adenocarcinoma containing a small number of neuroendocrine cells is a relatively frequent occurrence, gastric neoplasms containing equal proportions of both cell types are rare.
CASE PRESENTATION
We present a case of composite exocrine (signet-ring cell)-neuroendocrine cell carcinoma, in which the neoplastic signet-ring cell exocrine and neuroendocrine constituents occurred in fairly equivalent amounts, whereas only the neuroendocrine carcinoma portion of the tumor represented the metastatic component. Light microscopy, immunohistochemical and electron microscopic findings are described, and the literature is reviewed.
CONCLUSION
This study confirms the ability of pluripotent precursor cells to differentiate into either adenocarcinoma or neuroendocrine tumor and, justifying the designation of composite exocrine-neuroendocrine cell carcinoma as the appropriate classification for this tumor. The protracted clinical course further supports the notion that composite signet-ring cell/neuroendocrine carcinoma tumors behave relatively less aggressively than the pure forms of the former cell type.
背景
混合(复合)外分泌-神经内分泌细胞癌被定义为肿瘤性腺外分泌和神经内分泌细胞类型的密切混合。虽然含有少量神经内分泌细胞的胃腺癌是一种相对常见的现象,但含有等量这两种细胞类型的胃肿瘤则很少见。
病例介绍
我们报告了一例复合外分泌(印戒细胞)-神经内分泌细胞癌,其中肿瘤性印戒细胞外分泌和神经内分泌成分的含量相当,而仅肿瘤的神经内分泌癌部分代表转移成分。描述了光镜、免疫组织化学和电子显微镜检查结果,并复习了文献。
结论
本研究证实了多能前体细胞分化为腺癌或神经内分泌肿瘤的能力,这证明将复合外分泌-神经内分泌细胞癌作为该肿瘤的适当分类是合理的。较长的临床病程进一步支持这样一种观点,即复合印戒细胞/神经内分泌癌肿瘤的行为相对不如前一种细胞类型的纯形式那样具有侵袭性。